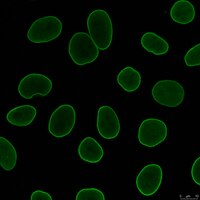
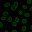

MABT1341-25UG Sigma-AldrichAnti-Lamin A/C Antibody, clone 4C11
Anti-Lamin A/C, clone 4C11, Cat. No. MABT1341, is a highly specific mouse monoclonal antibody that targets Lamin A/C and has been tested for use in Immunofluorescence, Immunoprecipitation, Chromatin Immunoprecipitation (ChIP), and Western Blotting.
More>> Anti-Lamin A/C, clone 4C11, Cat. No. MABT1341, is a highly specific mouse monoclonal antibody that targets Lamin A/C and has been tested for use in Immunofluorescence, Immunoprecipitation, Chromatin Immunoprecipitation (ChIP), and Western Blotting. Less<<Recommended Products
Overview
| Replacement Information |
|---|
| References |
|---|
| Product Information | |
|---|---|
| Format | Purified |
| Presentation | Purified mouse monoclonal antibody IgG2a in buffer containing 0.1 M Tris-Glycine (pH 7.4), 150 mM NaCl with 0.05% sodium azide. |
| Physicochemical Information |
|---|
| Dimensions |
|---|
| Materials Information |
|---|
| Toxicological Information |
|---|
| Safety Information according to GHS |
|---|
| Safety Information |
|---|
| Storage and Shipping Information | |
|---|---|
| Storage Conditions | Stable for 1 year at 2-8°C from date of receipt. |
| Packaging Information | |
|---|---|
| Material Size | 25 μg |
| Transport Information |
|---|
| Supplemental Information |
|---|
| Specifications |
|---|
| Global Trade ITEM Number | |
|---|---|
| Catalogue Number | GTIN |
| MABT1341-25UG | 04054839577086 |
Documentation
Anti-Lamin A/C Antibody, clone 4C11 MSDS
| Title |
|---|
Anti-Lamin A/C Antibody, clone 4C11 Certificates of Analysis
| Title | Lot Number |
|---|---|
| Anti-Lamin A/C, clone 4C11 - 4059361 | 4059361 |
| Anti-Lamin A/C, clone 4C11 Monoclonal Antibody | 3120373 |